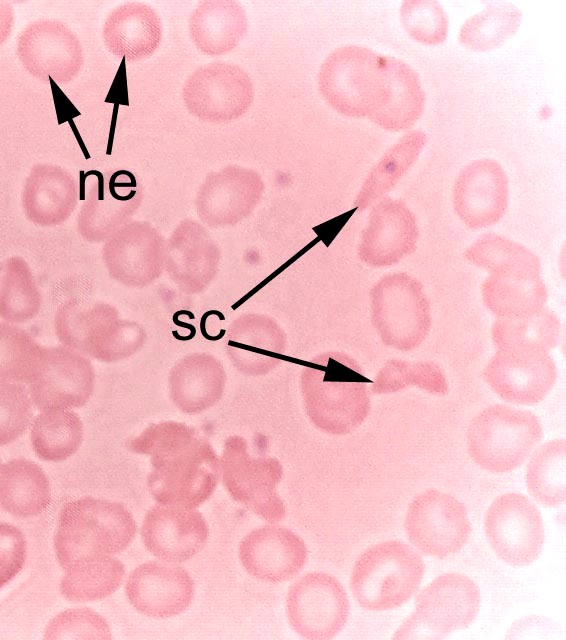

Einleitung
Ein Schmankerl für tauchmedizinisch tätige Kollegen, fürsorgliche Eltern und interessierte Taucher: Sichelzellanämie und Tauchtauglichkeit
Was haben Tabea, Mike, Yasmin, Joshua und Karim gemeinsam (Namen von der Autorin geändert)? Sie sind alle zwischen 11 und 34 Jahre alt und in Deutschland aufgewachsen. Sie möchten alle einmal kleine und große Taucher werden. Sie haben jedoch noch eine andere Gemeinsamkeit: ihr Erbgut stammt nicht aus Europa. Karim hat iranische Eltern und wurde in Deutschland geboren. Mike und Joshua wurden im Babyalter von deutschen Eltern adoptiert und stammen aus Afrika (Uganda, Kongo). Auch Yasmin ist ein Adoptivkind – sie wurde jedoch in Pakistan geboren. Tabea kam mit ihren Eltern als Kind aus Tansania nach Deutschland und ist Anästhesistin.
Alle können klasse schwimmen und fühlen sich im Wasser wohl. Alle sind „prima vista gesund“ und körperlich durchschnittlich fit. Hört sich eigentlich nach dem ganz normalen Durchschnitt an. Und trotzdem: was macht diese Menschen in Bezug auf eine Tauglichkeitsuntersuchung so besonders? Es ist ihr Erbgut aus „äquatornahen“ Ländern. Länder, in denen Malaria endemisch (also örtlich begrenzt auftretend) ist und in denen auch die sogenannte Sichelzellanämie gehäuft vorkommt.

Was ist Sichelzellanämie?
Die Sichelzellanämie ist eine Erbkrankheit, bei der durch einen Gendefekt anormales Hämoglobin (roter Blutfarbstoff) als Bestandteil der roten Blutkörperchen (Erythrozyten) gebildet wird. Das führt dazu, dass sich die roten Blutkörperchen verändern und sichelförmig werden. Die Sichelzellanämie gehört zu den sogenannten hämolytischen Anämien, d. h. die roten Blutkörperchen erreichen ihre normale Lebensdauer (120 Tage) nicht, wodurch eine Blutarmut mit Symptomen wie Müdigkeit, Infektanfälligkeit und Leistungsabfall entsteht – typische Symptome bei einer Anämie. Die Sichelzellanämie hat jedoch noch schlimmere Folgen:
Durch die Sichelform der Erythrozyten kann es bei einer schweren Ausprägung zu einer gefährlichen Verstopfung der kleinen Blutgefäßen führen. Diese Komplikation tritt meist während sogenannter Sichelzellkrisen auf, wenn plötzlich deutlich mehr Erythrozyten ihre Form ändern und so verklumpen.


Auslöser sind zum Beispiel ein Sauerstoffmangel, wie dies in der Höhenluft oder bei körperlicher Anstrengung der Fall sein kann sowie bei Kälte, Infekten und Entzündungen. Durch wiederholte Sichelzellkrisen oder unbemerkte kleine Gefäßverschlüsse kommt es schließlich zu schweren Langzeitschäden in verschiedensten Organen (Gehirn, Lunge, Augen, Niere, Milz etc. …). Zudem tut eine Sichelzellkrise richtig weh. Die Betroffenen leiden unter starken Schmerzen meist im Bauch- oder Brustkorbbereich und/oder an den Gelenken.
Die Erbkrankheit wird autosomal vererbt, d. h. unabhängig von den Geschlechtschromosomen. Chromosomen liegen immer paarweise vor. Bekommt ein Mensch nur ein krankes Chromosom von einem der Elternteile vererbt und hat dazu ein normales Chromosom, bildet er gleichzeitig normales (HbA) und abnormales (HbS) Hämoglobin im Verhältnis 1:1. Solche sogenannten „heterogenen Träger“ werden nur dann krank wenn der Ausbruch der Erkrankung durch bestimmte Faktoren getriggert wird (Sauerstoffmangel, Kälte, Anstrengung, Infektionen etc. …). Ist ein Mensch ein sogenannter homozygoter Träger mit zwei anormalen Chromosomen, wird ausschließlich HbS gebildet. Schon die normalen physiologischen Bedingungen reichen aus um eine Verformung der roten Blutkörperchen auszulösen. Die Sichelzellen verhaken sich leicht und führen zu den o. g. Komplikationen.
Und warum sollte man nun gerade Tabea, Mike, Yasmin, Joshua und Karim auf Sichelzellanämie testen und andere Kinder oder Erwachsene nicht?
Die Sichelzellanämie hat die größte Verbreitung in den Malariagebieten Afrikas und Asiens. Und genau von dort stammt das Erbgut unserer fünf Tauchaspiranten.
In Äquatorialafrika sind 25–40 % der Bevölkerung heterozygote Merkmalsträger. Die Häufigkeit des Defekts nimmt mit dem Abstand zum Äquator deutlich ab. Bei der schwarzen Bevölkerung Amerikas liegt die Häufigkeit nur noch zwischen 5 und 10 %. Dieses Phänomen lässt sich dadurch erklären, dass heterozygote Merkmalsträger eine relative Resistenz gegen Malaria besitzen – ein Umstand, der in Malariagebieten einen deutlichen Selektionsvorteil darstellt. In gemäßigten Breiten ist der Selektionsvorteil aufgrund der fehlenden Malaria nicht wirksam. Wenigstens ein wenig Gutes hat diese Erkrankung am Ende also doch.
Diagnostik: Erste Hinweise ergibt die Familiengeschichte. Die Diagnose wird laborchemisch anhand eines Differentialblutbildes (Vorhandensein sogenannter Targetzellen) gestellt und sollte im Weiteren durch spezielle Sichelzelltests ergänzt werden (Hämoglobin-Elektrophorese Restriktionsanalyse).
Und was hat das alles mit dem Tauchsport und der Tauchtauglichkeit zu tun?
Selbst im wärmsten Gewässer und im erholsamsten Tauchurlaub sind Kälte, Anstrengung, Infekte, körperlicher Stress und Dehydration ständige Begleiter eines Tauchers. Damit hat man schon einmal die gängigen Verdächtigen unter den auslösenden Faktoren mit an Bord, die eine Sichelzellkrise auslösen können. Zudem wissen wir nicht wie die Sichelzellform der roten Blutkörperchen als Haupttransporteur für Sauerstoff die Sättigungskinetik für Stickstoff beeinflusst.
Homozygote Träger (2 anormale Chromosomen) sind streng vom Tauchsport ausgeschlossen. Bei heterozygoten Trägern, die im Alltag sonst gesund sind, ist der Sichelzelltest im Labor ausschlaggebend. Nehmen die Erythrozyten unter Sauerstoffabschluss eine Sichelzellform an, sollte nicht getaucht werden. Ist dies nicht der Fall, muss die Tauchtauglichkeit trotzdem eingeschränkt werden und der Proband eingehend über die Risiken aufgeklärt sein. Tauchen in kalten Gewässern, Eistauchen und alle anstrengenden Tauchgänge (z. B. Bergungen) sind zu vermeiden. Berufstaucher und Kinder bis 18 Jahre erhalten keine Tauchtauglichkeit. Die Tauchtauglichkeitsuntersuchung wird jährlich durchgeführt – egal in welchem Alter – und im Spektrum je nach Krankheitsausprägung erweitert (Ultraschall von Bauch und Herz, Augen, Nieren etc. …)
In Deutschland sind jährlich etwa 300 Kinder und Erwachsene von der Sichelzellerkrankung betroffen. Meist handelt es sich um Einwanderer aus Malaria- Endemiegebieten oder um adoptierte Kinder. Insgesamt ist die Sichelzellanämie eine nicht sehr häufig vorkommende Fragestellung in einer tauchmedizinischen Sprechstunde. Der Taucherarzt muss aber im Einzelfall daran denken und es schadet auch nichts wenn in der Tauchschule bei den entsprechenden Tauchschülern danach gefragt wird!
